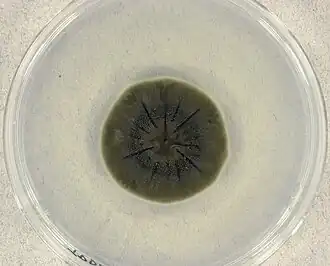

Кладоспорий
| Кладоспорий | ||||||||||||
|---|---|---|---|---|---|---|---|---|---|---|---|---|
| ||||||||||||
| Научная классификация | ||||||||||||
|
Домен: Царство: Подцарство: Отдел: Подотдел: Класс: Подкласс: Дотидеомицетовые Порядок: Капнодиальные Семейство: Cladosporiaceae Род: Кладоспорий |
||||||||||||
| Международное научное название | ||||||||||||
| Cladosporium Link, 1816 | ||||||||||||
| Типовой вид | ||||||||||||
| ||||||||||||
Кладоспо́рий, также кладоспо́риум (лат. Cladosporium), — род грибов, входящий в класс Дотидеомицеты.
Характеризуется тёмноокрашенным мицелием, на котором образуются разветвлённые цепочки тёмноокрашенных бластоконидий.
Широко распространённые сапротрофы различных природных субстратов.
Описание

Анаморфная стадия представлена тёмноокрашенными гифомицетами, в природных условиях образующими точечные или распростёртые колонии оливково-чёрных или чёрно-коричневых тонов, реже серо-оливковые. Гифы ветвящиеся, септированные, обычно гладкостенные, реже шероховатые. Стромы образуются не у всех видов. Конидиеносцы одиночные или в пучках, прямые или изогнутые, близ верхушки нередко узловатые или зубчатые, обычно пигментированные. Ветвление конидиеносцев обычно голобластическое, как правило, симподиальное. Конидиогенные клетки конечные или интеркалярные, обычно цилиндрические. Конидии (бластоконидии) одиночные или образующие разветвлённые цепочки (в культурах чаще образуются цепочки конидий). Обычны амероконидии, также с возрастом из первых конидий иногда образуются фрагмоконидии; форма конидий варьирует от почти шаровидной и яйцевидной до эллиптической, лимоновидной, цилиндрической.
Телеоморфа (типа Davidiella) образует шаровидными псевдотеции чёрного до красно-коричневого цвета, неясные и скрытые в строме или же выраженные и располагающиеся на редуцированной строме. Аски собраны в пучки, битуникатные, неокрашенные, септированные, с восемью спорами. Псевдопарафизы часто имеются, цилиндрические, септированные. Аскоспоры в двух и более рядах, неокрашенные, обратнояйцевидные до эллиптически-веретеновидных, иногда немного изогнутые.
Экология
Большинство видов — сапротрофы, встречающихся на различных остатках растительного и животного происхождения, некоторые виды — паразиты.
Систематика
Синонимы
Виды
Род включает около 150 видов. Некоторые из них:
- Cladosporium cladosporioides (Fresen.) G.A.de Vries — Кладоспорий кладоспориевидный
- Cladosporium cucumerinum Ellis & Arthur — Кладоспорий огурцовый
- Cladosporium herbarum (Pers.) Link — Кладоспорий травяной
- Cladosporium macrocarpum Preuss — Кладоспорий крупноплодный
- Cladosporium variabile (Cooke) G.A.de Vries — Кладоспорий изменчивый
Литература
- Behnsch K., Braun U., Groenewald J. Z., Crous P. W. The genus Cladosporium // Studies in Mycology. — 2012. — Vol. 72(1). — P. 1—401. — doi:10.3114/sim0003.